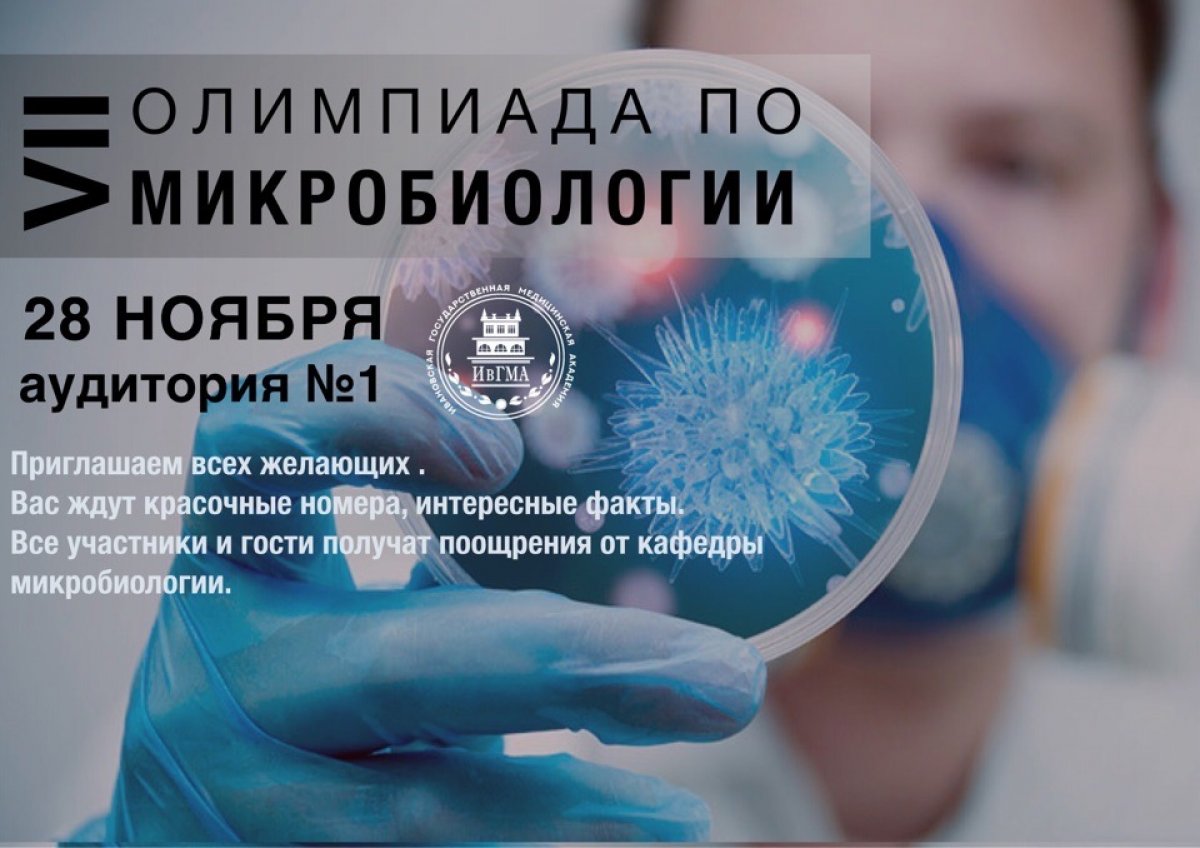
Уважаемые студенты и преподаватели!

Уважаемые студенты и преподаватели!
Приглашаем Вас стать зрителями VII олимпиады по микробиологии, которая состоится 28 ноября в 16:00 в аудитории №1.
Ждём Вас!
Уважаемые студенты и преподаватели!
Приглашаем Вас стать зрителями VII олимпиады по микробиологии, которая состоится 28 ноября в 16:00 в аудитории №1.
Ждём Вас!